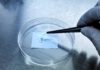
ฟรุตต้า ไบโอเมด Seed funds 50 ล้าน ปั้นสตาร์ทอัพ ‘ReLIFE’ สร้างโรงงานผลิตกระจกตาเทียมชีวภาพ

เริ่มแล้ว! OIC InsurTech Award 2025 จัด Roadshow เฟสแรก นำร่องมหาวิทยาลัยชั้นนำ จุดประกายไอเดีย เฟ้นหาสุดยอดนวัตกรรมด้านเทคโนโลยีประกันภัย
นางมยุรินทร์ สุทธิรัตนพันธ์ ผู้ทรงคุณวุฒิพิเศษ สำนักงานคณะกรรมการกำกับและส่งเสริมการประกอบธุรกิจประกันภัย (สำนักงาน คปภ.) เปิดเผยว่า สำนักงาน คปภ. โดยศูนย์ส่งเสริมเทคโนโลยีด้านการประกันภัย (CIT) เดินหน้าส่งเสริมการพัฒนานวัตกรรมในอุตสาหกรรมประกันภัยไทย ผ่านโครงการ OIC InsurTech Award อย่างต่อเนื่อง เพื่อสร้างความรู้ ความเข้าใจ และทักษะด้านเทคโนโลยีประกันภัยแก่กลุ่มนิสิต นักศึกษา บุคลากรในธุรกิจประกันภัย กลุ่ม Tech Firm Tech Startup และประชาชนทั่วไป โดยมีเป้าหมายในการผลักดันให้เกิดนวัตกรรมด้านเทคโนโลยีประกันภัยที่สามารถนำไปใช้ได้จริง เพิ่มโอกาสทางธุรกิจ และยกระดับคุณภาพของระบบประกันภัยของประเทศไทยให้เท่าทันกับการเปลี่ยนแปลงในยุคดิจิทัล
ผู้ทรงคุณวุฒิพิเศษ กล่าวเพิ่มเติมว่า โครงการนี้เป็นเวทีสำคัญที่เปิดโอกาสให้นิสิตนักศึกษาได้แสดงศักยภาพผ่านการแข่งขันและการนำเสนอแนวคิดนวัตกรรมด้านเทคโนโลยีประกันภัย ซึ่งหลายผลงานสามารถต่อยอดไปใช้จริงในภาคธุรกิจได้อย่างมีประสิทธิภาพ โดยในเฟสแรกของกิจกรรม OIC InsurTech Roadshow ได้ลงพื้นที่มหาวิทยาลัยชั้นนำทั้งในกรุงเทพมหานคร และปริมณฑล เพื่อถ่ายทอดความรู้เรื่องการประกันภัย วงจรธุรกิจประกันภัย และการประยุกต์ใช้เทคโนโลยีในอุตสาหกรรมประกันภัย โดยได้รับความร่วมมือจากผู้บริหารสถาบันการศึกษาอย่างดียิ่ง และมีนิสิตนักศึกษาเข้าร่วมกว่า 500 ราย พร้อมทั้งจัดเวทีบรรยายให้ความรู้ในหัวข้อ “Insurance Value Chain : Transforming Insurance with Technology” และกิจกรรม Workshop สร้างสรรค์และระดมความคิดนวัตกรรม พร้อมบอกเล่าเทคนิคการจัดทำ Pitch Deck และ Business Model Canvas เพื่อเตรียมความพร้อมสู่เวทีประกวด OIC InsurTech Award 2025 มุ่งเฟ้นหานักพัฒนานวัตกรรมด้านเทคโนโลยีประกันภัยรุ่นใหม่และกระตุ้นความตื่นตัวในกลุ่มนักศึกษาอย่างแท้จริง สำหรับในส่วนของโครงการ OIC InsurTech Roadshow เฟสที่ 2 ขณะนี้อยู่ระหว่างการเร่งสร้างความตระหนักรู้ และส่งเสริมการพัฒนานวัตกรรมเทคโนโลยีประกันภัยในทุกภาคส่วนของประเทศ โดยเฉพาะในกลุ่มเยาวชนและสถาบันการศึกษาทั่วประเทศ โดยได้เปิดรับสมัครผลงานเพื่อเข้าร่วมการประกวด OIC InsurTech Award 2025 ตั้งแต่วันนี้ ไปจนถึงวันที่ 30 มิถุนายน 2568 ผู้ที่สนใจสามารถศึกษารายละเอียดเพิ่มเติมและสมัครเข้าร่วมโครงการได้ที่เว็บไซต์ https://cit.oic.or.th/insurtechaward2025.html
“สำนักงาน คปภ. ขอขอบคุณคณะผู้บริหารและอาจารย์จากมหาวิทยาลัยต่าง ๆ รวมถึงวิทยากรและผู้เกี่ยวข้องทุกภาคส่วนที่มีส่วนสนับสนุนให้กิจกรรม Roadshow ครั้งนี้ ประสบความสำเร็จเป็นอย่างดี สำนักงาน คปภ. มุ่งหวังเป็นอย่างยิ่งว่า ความรู้และแรงบันดาลใจที่ได้จากกิจกรรมนี้ จะเป็นจุดเริ่มต้นให้เกิดนวัตกรรมด้านเทคโนโลยีประกันภัยใหม่ ๆ ที่สามารถพลิกโฉมและยกระดับอุตสาหกรรมประกันภัยไทยสู่อนาคตที่ยั่งยืน” ผู้ทรงคุณวุฒิพิเศษ กล่าวในตอนท้าย